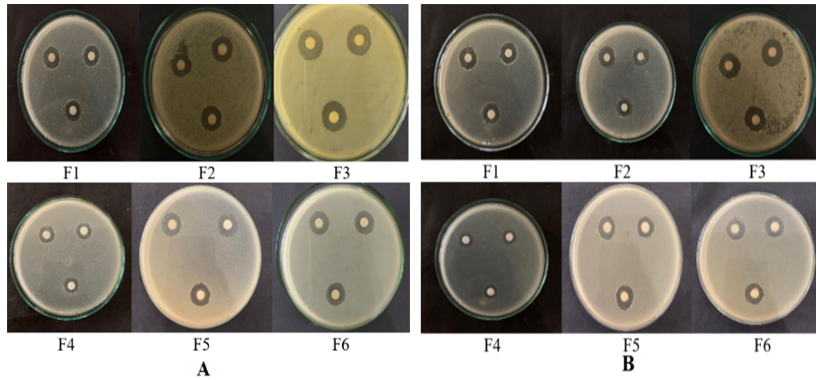

Int J App Pharm, Vol 17, Issue 2, 2025, 376-383Original Article
ANTIBACTERIAL AND ANTI-INFLAMMATORY ACTIVITIES OF NANOSIMPLICIA PHYLLANTUS EMBLICA L. FRUIT IN SUSPENSION FORMULATION
MASFRIA1, SUMAIYAH2, HAFID SYAHPUTRA1*, SILVIA3
1Department of Pharmaceutical Chemistry, Faculty of Pharmacy, Universitas Sumatera Utara, Medan, Indonesia. 2Department of Pharmaceutics and Pharmaceutical Technology, Faculty of Pharmacy. Universitas Sumatera Utara, Medan, Indonesia. 3Undergraduate Program, Faculty of Pharmacy, Universitas Sumatera Utara, Medan, Indonesia
*Corresponding author: Hafid Syahputra; *Email: hafid@usu.ac.id
Received: 08 Sep 2024, Revised and Accepted: 17 Dec 2024
ABSTRACT
Objective: Phyllanthus emblica L. fruit, rich in phenolic content, has been traditionally used for its medicinal properties, including antibacterial and anti-inflammatory effects. This study aimed to formulate and evaluate the antibacterial and anti-inflammatory activities of nanosimplicia derived from Phyllanthus emblica L. fruit in suspension form. The objectives were to determine the optimal formulation method based on physical stability and bioactivity and assess the resulting suspension's stability and therapeutic efficacy.
Methods: Nanosimplicia were prepared using ionic gelation, with varying concentrations of chitosan and sodium tripolyphosphate. The optimal formulation was selected based on the highest stability and bioactivity performance. The formulation was evaluated for physical stability, pH, organoleptic properties, and bioactivity against Staphylococcus aureus and Escherichia coli. Anti-inflammatory activity was assessed using the protein denaturation inhibition method with Bovine Serum Albumin (BSA).
Results: The optimal suspension formula (F3), consisting of 200 mg/ml nanosimplicia, 0.25% chitosan, and 0.1% sodium tripolyphosphate, exhibited significant antibacterial activity, with inhibition zones of 15.66 mm for Staphylococcus aureus and 15.53 mm for Escherichia coli (p<0.05). The anti-inflammatory activity showed 29.70% inhibition at 5 mg/l. F3 was chosen as the optimal formulation due to its superior bioactivity and stability over 30 d, maintaining a pH of 5–6 and stable organoleptic properties.
Conclusion: Phyllanthus emblica L. fruit nanosimplicia in suspension form demonstrated potent antibacterial and anti-inflammatory properties, making it a promising candidate for therapeutic applications targeting bacterial infections and inflammation.
Keywords: Antibacterial, Anti-inflammatory, Formulation, Nanosimplicia, Phyllanthus emblica L
© 2025 The Authors. Published by Innovare Academic Sciences Pvt Ltd. This is an open access article under the CC BY license (https://creativecommons.org/licenses/by/4.0/)
DOI: https://dx.doi.org/10.22159/ijap.2025v17i2.52608 Journal homepage: https://innovareacademics.in/journals/index.php/ijap
INTRODUCTION
Phyllanthus emblica L. fruit has a sour taste and functions as a cooling, astringent, rejuvenating, and antipyretic. It is also a traditional medicine to treat sore throat, cough, dry mouth, diarrhoea, jaundice, inflammation, diabetes mellitus, constipation, and asthma. Phyllanthus emblica L. fruit is a significant fruit and herb commonly utilized in traditional medicine, such as Chinese herbal therapy. Phyllanthus emblica L. fruit is traditionally used as a medicine and tonic [1, 2].
Phyllanthus emblica L. is a traditional medicinal plant belonging to the genus Phyllanthus, commonly cultivated in tropical and subtropical regions. The chemical components of the fruit are polyphenols, carbohydrates, proteins, and minerals, considered important bioactive compounds underlying its antioxidant and anti-inflammatory capacity. The fruit of Phyllanthus emblica includes phenolic chemicals, including geraniin, quercetin 3-β-D-glucopyranoside, kaempferol 3-β-D-glucospiranoside, isochocorlagin, quercetin, and kaempferol. Apeganine compounds and ascorbic acid have also been found in Phyllanthus emblica [3, 4].
In recent years, nanosuspension technology has emerged as a promising approach in drug delivery systems, particularly for enhancing the bioavailability of plant-derived bioactive compounds. Nanosuspensions offer several advantages, including increased surface area, improved solubility, enhanced absorption, and more efficient drug delivery to targeted cells. Studies have shown that nanosuspensions can enhance the therapeutic potential of both synthetic and natural drugs. However, despite the growing interest in this technology, limited research has focused on nanosuspensions formulated from traditional medicinal plants like Phyllanthus emblica, especially their antibacterial and anti-inflammatory activities [5, 6].
One innovative approach in this field is using nanosimplicia technology, where plant-derived particles, ranging in size from 1 to 1000 nanometers, are prepared to improve poor bioavailability, modify drug delivery systems, increase the stability of active substances, and enhance absorption. The primary goal of nanosimplicia design is to isolate and preserve the chemical compounds of Phyllanthus emblica fruit, thereby maximizing their biological activity. As the particle size decreases, the surface area increases, leading to faster dissolution rates, improved drug absorption, and targeted delivery to specific cells. Nanosimplicia can be formulated into suspension preparations, where the active particles are dispersed in a solvent without damaging their chemical content. This makes nanosimplicia technology a viable option for optimizing drug delivery, especially in oral and topical formulations and offers a promising avenue for developing plant-based therapeutic agents [3, 4].
Nanosimplicia suspensions, dispersions of tiny solid particles in a liquid medium for oral or topical use, differ from ordinary suspensions due to their particle size distribution, typically below 1 µm, with an average size ranging between 200 and 600 nm. These nanosuspensions offer superior bioavailability and stability compared to traditional formulations, making them an ideal dosage form for delivering active plant-derived compounds. Previous studies have demonstrated that plant-based nanosuspensions can significantly enhance antibacterial and anti-inflammatory activities. However, the specific bioactivity of Phyllanthus emblica nanosimplicia suspensions has not been thoroughly investigated, presenting a research gap in optimizing such formulations. Testing the antibacterial and anti-inflammatory activities of Phyllanthus emblica nanosimplicia suspensions in vitro has shown promising results, but further comprehensive studies are needed to fully understand their therapeutic potential and refine their formulation for maximum efficacy [5, 6].
Bacterial infection occurs when germs invade and harm human tissue. Gram-positive bacteria, such as Staphylococcus aureus, and g-negative bacteria, such as Escherichia coli, are the types of bacteria that cause infection. Inflammation is a characteristic of an infection. Inflammation is an immunological reaction that acts as a defence mechanism in response to an injury. Inflammation triggers the production of inflammatory chemicals that form free radicals at the site of inflammation. These free radicals, such as hydroxyl radicals, superoxide anion radicals, and hydrogen peroxide, function as signalling molecules and agents of inflammation. Excessive levels of Reactive Oxygen Species (ROS) during severe inflammatory conditions can lead to oxidative stress and tissue damage, hence playing a role in the development various inflammatory diseases [6].
Treatment of infectious diseases can use antibiotics, but inappropriate use of antibiotics can cause resistance, so traditional medicine becomes an alternative that can be used, one of which is by utilizing plants as drugs that can help deal with health problems. As a drug has a minimal effect compared to synthetic drugs with a more significant effect, but the cost is relatively expensive, many people prefer to use plants as medicine [7].
This study addresses this gap by evaluating the antibacterial and anti-inflammatory activities of Phyllanthus emblica nanosimplicia suspensions. The primary objective is to formulate an optimal suspension and test its bioactivity against Staphylococcus aureus and Escherichia coli. The secondary objectives are to assess the suspension's physical stability (pH, organoleptic properties) over 30 d and its anti-inflammatory potential using the protein denaturation inhibition method with BSA.
MATERIALS AND METHODS
Chemicals and reagents
The tools used in this study were glassware such as beaker glass (Iwaki), Erlenmeyer (Iwaki), measuring cups (Pyrex), and petri dishes. The instruments used were an incubator (Memmert IN55), analytical balance (Fujitsu FS-AR 210), autoclave (Daihan WAC-47), oven (Memmert UN55), UV-Vis spectrophotometry (Shimadzu-1800), Fourier Transform Infra Red Spectrophotometer (Shimadzu-IR Prestige 21) and micropipette (Eppendorf).
The materials and reagents used in this study were pro-analytical quality materials and reagents obtained from Merck and Sigma-Aldrich, such as chitosan, sodium tripolyphosphate, dimethyl sulfoxide, acetic acid, Mueller-Hinton Agar (MHA), Nutrient Agar media, Nutrient Broth media, BSA and methanol. Other ingredients such as diclofenac sodium, distilled water, Staphylococcus aureus and Escherichia coli bacteria were obtained from the USU faculty of pharmacy laboratory, and the fruit of Phyllanthus emblicaL., collected from Badung District, Bali. Sample identification was conducted at the Medanense Herbarium, specifically at the Herbarium Laboratory of the Faculty of Mathematics and Natural Sciences of Universitas Sumatera Utara (5581/MEDA/2021). The sampling was performed purposively, without comparison to other plants. The collected fruits were thoroughly washed with running water to remove impurities and then dried at 40-50 °C until they became brittle. Once dried, the Phyllanthus emblica fruit, now called Simplicia, was pulverized using a blender. The resulting powder was stored in an airtight plastic container to maintain stability and prevent contamination.
Nanosimplicia preparation
Simplicia powder was grounded using a high-energy ball mill at 400 rpm for 8 h. The manufacture of nanosimpliciaPhyllanthus emblica was carried out at PT—Indonesian Herbal Nanotech. The nanosimplicia characterization of Phyllanthus emblica fruit was carried out using a Particle Size Analyzer at PT. Indonesian Herbal Nanotech is characterized using FTIR and SEM.
Suspension preparation
In the suspension formulation, the composition of the ingredients in the suspension was taken from previous studies. The researcher manufactured and evaluated chitosan-sodium tripolyphosphate nanosimplicia suspensions based on previous research. Furthermore, this study modified the formula from arozal et al. (2021) by adding Phyllanthus emblica fruit nanosimplicia as an active ingredient. However, a preliminary test was conducted to determine the best material composition to obtain a stable suspension. Preliminary tests were conducted with variations in the concentration of chitosan and sodium tripolyphosphate [8]. The percentage composition of the ingredients in the suspension formulation modified from arozal et al. (2021) research, based on the orientation of the formula, can be seen in table 1.
Table 1: Composition of materials in the suspension of Phyllanthus emblica fruit nanosimplicia
| Ingredient | Formula | |||||
| F1 | F2 | F3 | F4 | F5 | F6 | |
| Chitosan (%) | 0.25 | 0.25 | 0.25 | 0.5 | 0.5 | 0.5 |
| Sodium Tripolyphosphate (%) | 0.1 | 0.1 | 0.1 | 0.1 | 0.1 | 0.1 |
| Phyllanthus emblica Fruit Nanosimplicia (mg/ml) | 100 | 150 | 200 | 100 | 150 | 200 |
A solution of chitosan in 1% acetic acid and sodium tripolyphosphate in distilled water was created by stirring with a magnetic stirrer for 8 h and sonicating for 40 min. Nanosimplicia were added to the sodium tripolyphosphate solution using a magnetic stirrer. A solution of chitosan was combined with nanosimplicia and sodium tripolyphosphate using a 1 ml syringe at a dropping rate of 15 drops per minute. The ratio of chitosan to sodium tripolyphosphate was 2:1. The solution was agitated for 8 h and treated with ultrasound for 45 min [8].
Evaluation of physical quality of preparations
Physical quality testing of suspension preparations includes the organoleptic examination of the suspension carried out by assessing changes in shape, colour, and odour for 30 d. The suspension sedimentation examines a centrifuge, and the pH is measured using a pH meter [9].
Antibacterial activity test
Placed bacterial inoculum onto a petri dish, followed by 15 ml of thawed sterile MHA, waited until the temperature reached 45 °C, mixed the contents, and let them set. After the media has solidified, the paper discs dropped on each test sample are placed. The concentrations of nanosimplicia used were 100, 150, and 200 mg/ml, the concentration of the chitosan-sodium tripolyphosphate suspension used were variations in the concentration of chitosan 0.25% and 0.5%, and the concentration of sodium tripolyphosphate 0.1%. Blanks were prepared using dimethyl sulfoxide without positive control. The concentrations of the Phyllanthus emblica fruit nanosimplicia suspension used were 0.25% and 0.5% chitosan concentrations, 0.1% sodium tripolyphosphate concentrations, and 100, 150, and 200 mg/ml variations in the concentration of nanosimplicia then incubated at 36–37 °C for one day. Furthermore, the inhibition area around the paper disc was measured using a capillary [10].
Anti-inflammatory activity test
Phyllanthus emblica fruit nanosimplicia suspension of about 500 mg was dissolved in 25 ml (20,000 mg/l) and then diluted to 1000 mg/l for each sample (test solution). 100 mg of diclofenac sodium was dissolved in methanol and diluted to 25 ml (4,000 mg/l), then further diluted to concentrations ranging from 500 to 4,000 mg/l to serve as the positive control solution. For the test and positive control solutions, 0.2% BSA solution was prepared by adding 5 ml (10 mg/l) for each suspension concentration and diclofenac sodium concentrations of 5, 10, 20, and 40 mg/l. After 30 min of incubation at 25 °C, the samples were heated at 72 °C for 5 min and then cooled to 23 °C for another 25 min. The absorbance was measured using UV-Vis spectrophotometry at 660 nm. The anti-inflammatory activity test was performed in triplicate to ensure reliability. Compounds that inhibit protein denaturation by more than 20% have significant anti-inflammatory properties and can be used as reference values for drug development [11].
The percentage of protein denaturation inhibition was measured using the following formula:

This method is based on the principle that protein denaturation is a crucial indicator of inflammation, and compounds that prevent this denaturation can be effective anti-inflammatory agents.
Statistical analysis
Data were analyzed using one-way ANOVA followed by Tukey's post-hoc test to compare antibacterial and anti-inflammatory activities across different nanosuspension concentrations. A sample size of n=3n = 3n=3 per group was chosen based on power analysis from prior studies to ensure sufficient power (0.80) for detecting medium effect sizes at a significance level of 0.05. Results are presented as mean±standard deviation (SD) with statistical significance set at p<0.05p<0.05p<0.05, and 95% confidence intervals (CI) provided to enhance result reliability. Assumptions of normality and homogeneity of variances were tested using the Shapiro-Wilk and Levene's tests, with non-parametric methods applied if assumptions were violated. Statistical analyses were conducted using SPSS to ensure accuracy and reproducibility.
Nanosimplicia
Simplicia fruit Phyllanthus emblica sent to PT. Nanotech Herbal Indonesia so that becomes nano size, and the size of the nanosimplicia obtained is 731±168 nm. Nanosimplicia are particles measuring 1 – 1000 nanometers, and so based on this statement, the measurement results show that the simplicia of Phyllanthus emblica fruit is in the nanosimplicia size range.

Fig. 1: Morphological results of nanosimplicia using SEM
The FTIR study findings are shown in fig. 2. Wave number 3304 cm−1 represents the stretching frequency of the −OH functional group, while 2902 cm−1 represents the −C−H functional group. The −C=O functional group has a stretching frequency of 1726 cm−1, the C-O (carbonyl) functional group has 1612 cm−1, and the −C− O−C functional group has 1341 cm−1.
Fig. 2: FTIR spectra of nanosimplicia

Suspension preparations
This suspension was made with variations of 0.25% and 0.5% chitosan concentrations, 0.1% sodium tripolyphosphate concentrations, and variations in the concentration of nanosimplicia 100, 150, and 200 mg/ml and then evaluated, the physical quality of the suspension concentration variations and the antibacterial effect of the suspension.
Evaluation of physical quality of preparations
Based on the results of organoleptic observations, there were no significant changes during the observation and storage of the preparations. The preparation's form, colour, and odour are stable, whereas all formulas F1 – F6 have a liquid, brown form and a characteristic odour from days 1 – 30. The organoleptic suspension on the 1st d and storage until the 30th d can be seen in fig. 3. The sedimentation test was carried out using a centrifuge at a speed of 6000 rpm for 2 h, and the sediment that occurred was observed. The test results showed that all formulas did not experience precipitation.
The results of measuring the pH of the suspension preparation at week 0 can be seen in table 2. The pH test of the formula has a pH range of 5.2-5.3, and the optimum suspension pH is 5-6 [4, 12].

Fig. 3: Preparation of suspension on day one and storage up to day 30
Table 2: Results of determination of pH
| Formula | pH |
| F1 | 5.24±0.16 |
| F2 | 5.23±0.11 |
| F3 | 5.2±0.12 |
| F4 | 5.3±0.17 |
| F5 | 5.27±010 |
| F6 | 5.25±0.14 |
n = 3; values are expressed as mean±SD
Antibacterial activity of Phyllanthus emblica fruit nanosimplicia
Phyllanthus emblica fruit nanosimplicia were dispersed in distilled water and tested for antibacterial activity. The results of the antibacterial activity test of nanosimplicia with varying concentrations of nanosimplicia 100, 150, and 200 mg/ml against the growth of Staphylococcus aureus and Escherichia coli bacteria can be observed in table 3.
Antibacterial activity of chitosan-sodium tripolyphosphate suspension
The findings from the antibacterial activity test of the chitosan-sodium tripolyphosphate suspension (0.25%) and chitosan (0.5%) on the growth of Staphylococcus aureus and Escherichia coli bacteria can be observed in table 4.
Antibacterial activity of nanosimplicia suspension
The antibacterial of the suspension of Phyllanthus emblica fruit nanosimplicia with variations in the concentration of nanosimplicia 100, 150, and 200 mg/ml against the growth of Staphylococcus aureus and Escherichia coli bacteria can be observed in table 5 and fig. 4.
Table 3: Test result for antibacterial activity of fruit nanosimpliciaPhyllanthus emblica
| Phyllanthus emblica fruit nanosimplicia concentration (mg/ml) | Inhibition zone diameter (mm) | |
| Staphylococcus aureus | Escherichia coli | |
| 100 | 10.5±0.6 | 10.06±0.56 |
| 150 | 11.8±0.4 | 11.23±0.17 |
| 200 | 12.8±0.3 | 12.13±0.67 |
| Blank (dimethyl sulfoxide) | - | - |
n = 3; values are expressed as mean±SD
Table 4: Test result for antibacterial activity of chitosan-sodium tripolyphosphate suspension
| Chitosan concentration (%) | Inhibition zone diameter (mm) | |
| Staphylococcus aureus | Escherichia coli | |
| 0.25 | 11.76±0.16 | 11.4±0.4 |
| 0.5 | 10.66±0.14 | 10.4±0.3 |
n = 3; values are expressed as mean±SD
Table 5: Test result for antibacterial activity of nanosimplicia suspension
| Formula | Inhibition zone diameter (mm) | |
| Staphylococcus aureus | Escherichia coli | |
| F1 | 14.23±0.23 | 14.06±0.44 |
| F2 | 15.3±0.1 | 14.9±0.1 |
| F3 | 15.66±0.16 | 15.53±0.27 |
| F4 | 12.1±0.4 | 11.7±0.1 |
| F5 | 13.26±0.56 | 12.86±0.44 |
| F6 | 13.66±0.36 | 13.6±0.5 |
n = 3; values are expressed as mean±SD

Fig. 4: Result for antibacterial activity of nanosimplicia suspension, n = 3; values are expressed as mean ±SD
Fig. 5: Test result for antibacterial activity of Phyllanthus emblica fruit nanosimplicia suspension against Staphylococcus aureus (A) and Escherichia coli (B) bacteria
The antibacterial activity of Phyllanthus emblica fruit nanosimplicia was tested, revealing that nanosimplicia exhibited inhibitory effects against Staphylococcus aureus and Escherichia coli bacteria. For Staphylococcus aureus, the inhibitory diameters were 10.5, 11.8, and 12.8 mm at 100, 150, and 200 mg/ml concentrations, respectively. For Escherichia coli, the inhibitory diameters were 10.06, 11.23, and 12.13 mm at 100, 150, and 200 mg/ml, respectively.
Anti-inflammatory activity of Phyllanthus emblica fruit nanosimplicia suspension
Anti-inflammatory activity was tested against protein denaturation by adding BSA solution. This method reduces the use of live specimens in the drug development process, as denaturation occurs when BSA is heated. Compounds that can stabilize proteins from the protein denaturation process are potential anti-inflammatory agents. There was an interaction between BSA and the active substance in the compound, resulting in the binding of the active substance with amino acids such as tyrosine, threonine, and lysine. When the active substance attaches to BSA, it stabilizes the protein structure and prevents BSA denaturation [13, 14].
Diclofenac sodium was used as a positive control due to its well-documented ability to inhibit the cyclooxygenase-2 (COX-2) isoenzyme more effectively than other NSAIDs. This inhibition reduces the production of prostaglandins, the mediators of inflammation, and lowers the intracellular concentration of free arachidonic acid in leukocytes. At concentrations of 5 mg/l, 10 mg/l, 20 mg/l, and 40 mg/l, diclofenac sodium demonstrated protein denaturation inhibition percentages exceeding 20%, confirming its anti-inflammatory solid activity (table 6). This benchmark allows for a direct comparison with the Phyllanthus emblica fruit nanosimplicia suspension, which exhibited a protein denaturation inhibition of 26.17% at 10 mg/l [15]. While the anti-inflammatory activity of the nanosimplicia suspension is lower than diclofenac sodium, it aligns well with other plant-based anti-inflammatory agents reported in the literature. For instance, curcumin-based nanosuspensions have demonstrated comparable inhibition levels, reinforcing the therapeutic relevance of Phyllanthus emblica as a natural anti-inflammatory agent. Additionally, the nanosuspension's ability to inhibit protein denaturation highlights its potential as a safer, plant-based alternative to synthetic NSAIDs, particularly for patients requiring long-term therapy with minimal side effects [12].
Table 6: Anti-inflammatory activity
| Concentration | Absorbance | Percent Inhibition (%) |
| Negative Control | 2.380±0.043 | 0.00±1.36 |
| Positive Control 5 mg/l | 2.149±0.018 | 29.70±1.08 |
| Positive Control 10 mg/l | 2.092±0.017 | 42.10±1.72 |
| Positive Control 20 mg/l | 2.081±0.022 | 47.56±0.78 |
| Positive Control 40 mg/l | 2.063±0.031 | 53.31±1.08 |
| Suspension 10 mg/l | 2.233±0.011 | 26.17±1.23 |
n = 3; values are expressed as mean±SD
DISCUSSION
The SEM results in fig. 1 display an irregular surface shape, uneven surface texture, and the presence of sharp and obtuse corners with particle sizes below 300 µm. Larger particles up to 1000 µm were also observed. This indicates that the milling process, while effective, may still leave larger particulates that could affect suspension uniformity, though they remain within the acceptable nanosimplicia size range (1-1000 nm) as stated in the literature. Identifying functional groups in P. emblica fruit simplicial nanosimplicia indicates polyphenolic compounds, pectin, and vitamin C. These bioactive compounds are critical contributors to the antibacterial and anti-inflammatory effects observed, as phenolic compounds have been well-documented for their ability to disrupt bacterial membranes and modulate inflammatory pathways.
In this study, the suspension was prepared using the ionic gelation method. This suspension formation method is based on electrostatic interactions between the amine groups of chitosan and the negative charge of polyanion groups such as tripolyphosphate. This technique offers a simple way. First, chitosan can be dissolved in acetic acid without a stabilizer that can be added to the chitosan solution before or after adding polyanions. The polyanion or anionic polymer is then added, and the nanosimplicia form spontaneously under mechanical stirring at room temperature [16].
The organoleptic examination helps determine the suspension preparations' shape, colour, and odour. An organoleptic assessment was conducted over a 30 d to observe any alterations in the suspension formulation's form, hue, and scent while in storage. Storage conditions for suspension preparations in transparent plastic containers stored in a cupboard at 30±2 °C and humidity 75±5%. There are many considerations in developing and manufacturing an excellent pharmaceutical suspension. One thing to note is that a properly prepared pharmaceutical suspension settles slowly and should flatten again when shaken. Various factors are involved in the rate of settling velocity of suspended particles, namely the gravitational constant, particle diameter, density of the dispersed phase, density of the dispersion medium, and viscosity of the dispersion medium [9]. The stability of the suspension, in terms of both physical appearance and pH, suggests that the formulation is robust enough for long-term storage, which is crucial for its potential pharmaceutical application.
In terms of the quality of growth inhibition, the criteria for antibacterial strength stated that an inhibition zone diameter of 5 mm or less had a weak category of antibacterial activity, 5-10 mm in the medium category, 10-20 mm in the strong category, and an inhibition zone diameter of 20 mm or more in the category very strong [17] Nanosimplicia has a large surface area that allows contact with higher walls of microorganisms. Nanosimplicia will approach the bacterial cell membrane and penetrate the bacterial cell during diffusion [18].
Table 4 demonstrates an inverse relationship between the concentration of chitosan and the diameter of the inhibition zone: as the concentration of chitosan increases, the diameter of the inhibition zone decreases. This is attributed to the increase in particle size of the nanosimplicia suspension with higher chitosan concentrations, which reduces the suspension's antibacterial activity. Several hypotheses are being developed to explain the antibacterial mechanism of chitosan. One hypothesis suggests that chitosan has a strong affinity for microbial DNA, allowing it to bind to DNA and subsequently interfere with mRNA and protein synthesis. The antimicrobial efficacy of chitosan against bacteria or microorganisms is influenced by its molecular weight and degree of deacetylation-higher molecular weight and degree of deacetylation correlate with increased antimicrobial activity [19].
Chitosan's amine functional group (–NH2) is positively charged and highly reactive, facilitating its attachment to the negatively charged bacterial cell wall. This attachment occurs at electronegative sites on the bacterial cell wall's surface, disrupting cell membrane integrity and leading to bacterial cell death. The –NH2 group can also bind Ca2+ions in the bacterial cell wall, forming a coordinating covalent link, further disrupting the cell wall structure. Gram-negative bacteria, which possess lipopolysaccharides in their outer layer, are particularly susceptible to chitosan due to their negative charge. The concentration of chitosan also affects the particle size of the nanosimplicia suspension. A higher concentration of chitosan results in larger particles, which can reduce the diffusion of the active antibacterial agents, thereby diminishing their efficacy. This explains the observed decrease in antibacterial activity with increasing chitosan concentration [20, 21].
Furthermore, the-NH2 group can bind Ca2+minerals in the bacterial cell wall by generating a coordinating covalent link due to its lone pair of electrons. Gram-negative bacteria possessing lipopolysaccharide in their outer layer have a negative charge and are susceptible to chitosan [14]. The concentration of 0.5% chitosan has a lower inhibitory power. This happens because the chitosan content of 0.25% concentration is less than 0.5% concentration (thicker), so the diffusion process of 0.25% concentration is better than 0.5% concentration and can suppress bacterial growth. The test is also affected by how quickly the antibacterial works [20, 21].
Table 5 and fig. 4 demonstrate that the antibacterial activity is directly proportional to the concentration of nanosimplicia, with higher concentrations resulting in larger inhibition zones. The nanosimplicia formulation at 200 mg/ml was particularly effective, demonstrating inhibition zones of over 15 mm. These results are consistent with other studies showing increased antibacterial efficacy with higher concentrations of plant-based nanosuspensions.
The active compounds in nanosimplicia and the chitosan coating may effectively inhibit microbial growth. Chitosan has significant potential as an antibacterial agent due to the presence of lysozyme enzymes and amino polysaccharide groups that can inhibit microbial growth. Modern studies have shown that Phyllanthus emblica L. possesses notable antioxidant, anti-inflammatory, antibacterial, and hepatoprotective properties [19, 22].
According to the Indonesian Pharmacopoeia Edition VI (2020), an effective suspension concentration for bacterial inhibition comprises 100 mg/ml nanosimplicia, 0.25% chitosan, and 0.1% sodium tripolyphosphate. This formulation demonstrated an inhibition zone diameter of 14.23 mm for Staphylococcus aureus and similar effectiveness against Escherichia coli at the same concentrations [23].
Regarding variability, the inhibition zone's SD was relatively small (±0.3 mm for both bacteria), indicating good consistency in the results. However, minor variability could be attributed to differences in the uniformity of bacterial inoculum on the agar plates and the precise placement of the paper discs. All tests were performed in triplicate to minimise such errors, and careful attention was given to standardizing the experimental conditions.
The anti-inflammatory effect observed with the nanosimplicia suspension is comparable to other studies on plant-derived anti-inflammatory agents. For instance, similar levels of protein denaturation inhibition have been reported in studies involving herbal formulations such as curcumin-based nanosuspensions. The lower inhibition is expected compared to diclofenac sodium, as synthetic non-steroidal anti-inflammatory drugs typically have more potent effects due to their specific action on COX-2 enzymes. Nonetheless, the results suggest that Phyllanthus emblica nanosimplicia could offer a natural alternative with fewer side effects compared to synthetic NSAIDs, making it relevant for further exploration as a therapeutic agent.
The Phyllanthus emblica fruit nanosimplicia suspension demonstrated a 26.17% inhibition of protein denaturation at a concentration of 10 mg/l. This indicates that the nanosimplicia suspension possesses anti-inflammatory properties, albeit somewhat less than diclofenac sodium. The results suggest that nanosimplicia from Phyllanthus emblica L. fruit can be a natural alternative for anti-inflammatory treatment, potentially reducing reliance on synthetic drugs and their associated side effects [13, 14].
The relevance of these findings becomes even more apparent when considering the growing interest in developing safer and more sustainable therapeutic options. Herbal-based nanosuspensions, like the one studied here, offer a viable alternative to synthetic drugs, especially for patients requiring long-term anti-inflammatory therapy with fewer adverse effects. The comparison with other plant-based formulations, such as curcumin nanosuspensions, reinforces the conclusion that nanosuspension technology can significantly improve the bioactivity of natural compounds. Future research should focus on refining the nanosimplicia preparation process to further reduce particle size and improve uniformity, as this could potentially enhance antibacterial and anti-inflammatory effects [24, 25].
CONCLUSION
This study successfully formulated Phyllanthus emblica L. fruit nanosimplicia in suspension form using ionic gelation, demonstrating significant antibacterial activity against Staphylococcus aureus and Escherichia coli, along with moderate anti-inflammatory potential (26.17% inhibition of protein denaturation). The nanosimplicia technology enhanced the bioavailability and efficacy of the natural compounds, with the suspension remaining stable over 30 d. This is the first application of ionic gelation for Phyllanthus emblica nanosimplicia, offering a novel delivery system for plant-based bioactive compounds. While the in vitro results are promising, future in vivo studies are necessary to confirm clinical relevance and refinements in particle size uniformity and sample sizes will further strengthen the findings. These results suggest a potential for Phyllanthus emblica nanosimplicia in natural therapeutic agents for bacterial infections and inflammation.
ACKNOWLEDGMENT
We are grateful to the University of Sumatera Utara for the financial support of TALENTA (230/UN5.2.3.1/PPM/SPP-TALENTA USU/2021) in conducting this study.
FUNDING
TALENTA funds this study.
AUTHORS CONTRIBUTIONS
M contributed to the conception and design of the study, as well as data interpretation. S was responsible for data acquisition and analysis. HS supervised the project, provided critical insights during data analysis, and led the drafting and revision process. Sv contributed to data interpretation and final revision of the manuscript. All authors have read and approved the final version of the manuscript and agree to be accountable for all aspects of the research.
CONFLICT OF INTERESTS
The authors declare no conflict of interest
REFERENCES
Prananda AT, Dalimunthe A, Harahap U, Simanjuntak Y, Peronika E, Karosekali NE. Phyllanthus emblica: a comprehensive review of its phytochemical composition and pharmacological properties. Front Pharmacol. 2023 Oct 26;14:1288618. doi: 10.3389/fphar.2023.1288618, PMID 37954853.
Ahmad B, Hafeez N, Rauf A, Bashir S, Linfang H Rehman M, Mubarak MS, Uddin MS, Bawazeer S, Shariati MA, Daglia M, Wan C, Rengasamy KR. Phyllanthus emblica: a comprehensive review of its therapeutic benefits. South African Journal of Botany. 2021 May;138-310. doi: 10.1016/j.sajb.2020.12.028.
Huang Z, WU L, Wang W, Zhou Y, Zhang X, Huang Y. Unraveling the publication trends in inhalable nanosystems. J Nanopart Res. 2021;24:10. doi: 10.1007/s11051-021-05384-1, PMID 35018138.
Ridwan F, Fadel M. Preparation of avocado leaf simplicia macro/nanoparticles by using high energy ball mill. IOP Conf Ser Mater Sci Eng. 2021;1041:12059. doi: 10.1088/1757-899X/1041/1/012059.
Masfria DA, Dalimunthe A, Syahputra H, Sumantri IB, Ersa F. Standardization study of simplicia nanoparticle from phyllanthus emblica l. fruit. AIP Conf Proc. 2023;2626:1. doi: 10.1063/5.0136118.
Masfria M, Sumaiyah S, Syahputra H, Witarman M. Formulation and evaluation of antibacterial and anti-inflammatory capsules containing Phyllanthus emblica L. fruit nanoparticles. Sci Technol Indones. 2023 Oct 1;8(4):607-15. doi: 10.26554/sti.2023.8.4.607-615.
Masfria SH, Syahputra HS, Wahyuni HS, Zebua NF, Elizabeth, Marcelynn. Analysis of total flavonoid and antioxidant activity of coconut shell liquid smoke (Cocos nucifera L.) as an antibacterial. Pharm Educ. 2024 Apr 1;24(2):39-45. doi: 10.46542/pe.2024.242.3945.
Arozal W, Louisa M, Rahmat D, Chendrana P, Sandhiutami NM. Development characterization and pharmacokinetic profile of chitosan sodium tripolyphosphate nanoparticles based drug delivery systems for curcumin. Adv Pharm Bull. 2021;11(1):77-85. doi: 10.34172/apb.2021.008, PMID 33747854.
Jang JG, Kang JH, Joe KB, Sakthiabirami K, Jang KJ, Jun MJ. Evaluation of physical properties of zirconia suspension with added silane coupling agent for additive manufacturing processes. Materials (Basel). 2022;15(4):1337. doi: 10.3390/ma15041337, PMID 35207878.
Lubis MF, Syahputra H, Astyka R. Antibacterial activity ethanolic extract of Ocimum basilicum L. leaves in inhibiting the growth of escherichia coli and pseudomonas aeruginosa. NSMRJ: Nusantara Scientific Medical Research Journal. 2022;1(1):1-8.
Chaithanya MV, Uma Maheswari TN, Rajeshkumar S. Anti-inflammatory and antioxidant activity of lycopene raspberry green tea herbal formulation mediated silver nanoparticle. J Indian Acad Oral Med Rad. 2021;33(4):397-400. doi: 10.4103/jiaomr.jiaomr_98_21.
Zafar F, Jahan N, Khalil UR Rahman AM, Asi M, Zafar WU. Nanosuspension enhances dissolution rate and oral bioavailability of terminalia arjuna bark extract in vivo and in vitro. Asian Pac J Trop Biomed. 2020;10(4):164. doi: 10.4103/2221-1691.280293.
Nirmala AR, Permatasari L, Muliasari H, Deccati RF. Review: analysis of optimal conditions of bovine serum albumin (BSA) protein denaturation inhibition method in anti-inflammatory activity testing of various plant leaf extracts. J Agritechnology Food Process. 2023;3(2). doi: 10.31764/jafp.v3i2.20953.
Douadi K, Chafaa S, Douadi T, Al Noaimi M, Kaabi I. Azoimine quinoline derivatives: synthesis classical and electrochemical evaluation of antioxidant anti-inflammatory antimicrobial activities and the DNA/BSA binding. J Mol Struct. 2020 Oct 5;1217:128305. doi: 10.1016/j.molstruc.2020.128305.
Abdulsattar AM, Hossain MA. Antibacterial and antioxidant potential of Tetraena simplex extracts of various polarities. Toxicol Rep. 2020;7:925-9. doi: 10.1016/j.toxrep.2020.07.014, PMID 32793421.
Gupta A, Badola A. Pharmaceutical suspension: a review. World J Pharm Res. 2022;11(3):1011-25. doi: 10.20959/wjpr20223-23318.
Masfria M, Sumaiyah S, Syahputra H, Jenifer J. Anti-inflammatory and anti-aging activity of hydrogel with active ingredient Phyllantus emblica L. fruit nanosimplicia. J Med Plants. 2023;22(88):49-64. doi: 10.61186/jmp.22.88.49.
Suci N, Masfria A, Dalimunthe, Hafid Syahputra. Characterization phytochemical screening of Phyllanthus emblica L. Fruit nanoherbal and determination of the estrus cycle of female rats. Int J Sci Technol Manag. 2023;4(1):191-6. doi: 10.46729/ijstm.v4i1.727.
Khubiev OM, Egorov AR, Kirichuk AA, Khrustalev VN, Tskhovrebov AG, Kritchenkov AS. Chitosan based antibacterial films for biomedical and food applications. Int J Mol Sci. 2023;24(13):10738. doi: 10.3390/ijms241310738, PMID 37445916.
Varghese M, Balachandran M. Antibacterial efficiency of carbon dots against gram-positive and gram-negative bacteria: a review. J Environ Chem Eng. 2021;9(6):106821. doi: 10.1016/j.jece.2021.106821.
Anees Ahmad S, Sachi Das S, Khatoon A, Tahir Ansari M, Afzal M, Saquib Hasnain M. Bactericidal activity of silver nanoparticles: a mechanistic review. Mater Sci Energy Technol. 2020;3:756-69. doi: 10.1016/j.mset.2020.09.002.
Krishnaveni M, Mirunalini S. Therapeutic potential of phyllanthus emblica (amla): the ayurvedic wonder. J Basic Clin Physiol Pharmacol. 2010;21(1):93-105. doi: 10.1515/jbcpp.2010.21.1.93, PMID 20506691.
Ministry of health of the republic of Indonesia. Indonesian pharmacopoeia. 6th ed. Ministry of Health of the Republic of Indonesia; 2020.
Liu Y, WU F, Ding Y, Zhu B, SU Y, Zhu X. Preparation and characterization of paclitaxel/chitosan nanosuspensions for drug delivery system and cytotoxicity evaluation in vitro. Adv Fiber Mater. 2019;1(2):152-62. doi: 10.1007/s42765-019-00012-z.
Shankar SJ, BH, JG, RS, A, Metikurki B, Rehamathulla M. A review on the role of nanocrystals and nanosuspensions in drug delivery systems. Int J App Pharm. 2019;12(1):10-6. doi: 10.22159/ijap.2020v12i1.35508.